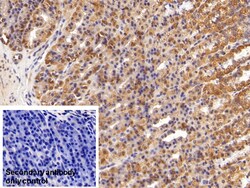
Invitrogen HMGB1 Polyclonal Antibody:Antibodies:Primary Antibodies

missing translation for 'onlineSavingsMsg'
Learn More
Learn More
Invitrogen™ HMGB1 Polyclonal Antibody


Rabbit Polyclonal Antibody
$336.24 - $821.34
Specifications
| Antigen | HMGB1 |
|---|---|
| Concentration | 0.5 mg/mL |
| Content And Storage | Store at 4°C short term. For long term storage, store at -20°C, avoiding freeze/thaw cycles. |
| Applications | Immunohistochemistry (Paraffin), Western Blot |
| Classification | Polyclonal |
| Catalog Number | Mfr. No. | Quantity | Price | Quantity & Availability | |||||
|---|---|---|---|---|---|---|---|---|---|
| Catalog Number | Mfr. No. | Quantity | Price | Quantity & Availability | |||||
PIPA5119192
 |
Invitrogen™
PA5119192 |
200 μL |
Each for $821.34
|
|
|||||
|
PIPA5121908
|
Invitrogen™
PA5121908 |
20 μL |
Each for $336.24
|
|
|||||
Description
HMGB1 Polyclonal Antibody for Western Blot, IHC (P)
High-mobility group box 1 protein, previously known as HMG-1 or amphoterin, is a member of the high mobility group box family of non-histone chromosomal proteins. Human HMGB1 is expressed as a 30 kDa, 215 amino acid (aa) single chain polypeptide containing three domains: two N-terminal globular, 70 aa positively charged DNA-binding domains (HMG boxes A and B), and a negatively charged 30 aa C-terminal region that contains only Asp and Glu. HMGB1 is expressed at high levels in almost all cells. It was originally discovered as a nuclear protein that could bend DNA. Such bending stabilizes nucleosome formation and regulates the expression of select genes upon recruitment by DNA binding proteins. It is now known that HMGB1 can also act extracellularly, both as an inflammatory mediator that promotes monocyte migration and cytokine secretion, and as a mediator of T cell-dendritic cell interaction. Moreover, HMGB1 is reported that the level of HMGB1 is elevated during sterile tissue injury, infection, lethal endotoxemia or sepsis, collagen-induced arthritis, and ischemia-reperfusion induced tissue injury.Specifications
| HMGB1 | |
| Store at 4°C short term. For long term storage, store at -20°C, avoiding freeze/thaw cycles. | |
| Polyclonal | |
| Liquid | |
| IgG | |
| Human, Mouse, Rat | |
| Hmgb1 | |
| Ac2-008; amphoterin; Amphoterin antibody; DEF; DKFZp686A04236; Heparin-binding protein p30; high mobility group 1; high mobility group 1 protein; high mobility group box 1; high mobility group protein 1; High mobility group protein B1; high mobility group protein HMG1; high-mobility group (nonhistone chromosomal) protein 1; high-mobility group box 1; high-mobility-group protein; Hmg1; HMG-1; HMG3; HMG3 antibody; hmgb 1; HMGB1; hmgb-1; HMGB1 protein; hypothetical protein; non-histone protein HMG1; p30; RCJMB04_15a21; RP11-550P23.1; SBP-1; Sulfoglucuronyl carbohydrate binding protein; unnamed protein product | |
| Hmgb1 | |
| Primary | |
| Antigen affinity chromatography, Protein A |
| 0.5 mg/mL | |
| Immunohistochemistry (Paraffin), Western Blot | |
| Unconjugated | |
| Rabbit | |
| RUO | |
| PBS with 50% glycerol and 0.05% ProClin 300; pH 7.4 | |
| P09429, P63158, P63159 | |
| 15289, 25459, 3146 | |
| Recombinant protein High Mobility Group Protein 1. The antigen corresponds to amino acid range 1-215 of the target protein. | |
| Antibody |